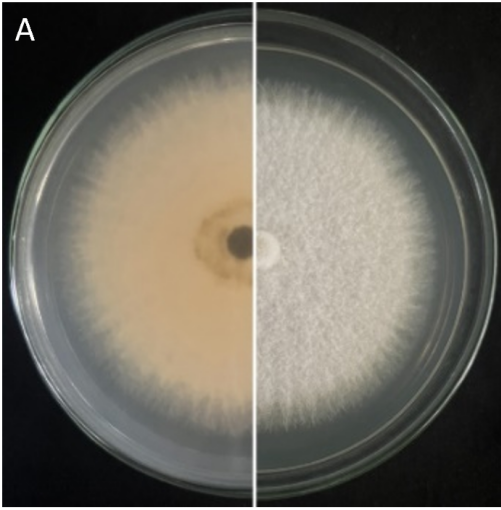

1.活动开展基本情况
一、依托研究生注册创办的现代农业公司,师生团队从专业角度出发,对当地产业进行调研,开展乡村振兴产业服务实践。
2021年3月,在昆明学院团队老师的带领下,由团队教师和在读农业类专业硕士研究生、在读本科生共同出资注册了创新创业型农业公司——云南耕雪农业科技限公司。公司位于迪庆州,集“农业科研及其成果推广示范、现代农业科普教育、绿色生态种植、农产品营销、生态农业休闲旅游康养”为一体的现代农业综合性开发公司。至今,在团队师生努力下,已在公司种植基地及合作基地种植了藜麦、奇异莓、甜百合、玫瑰、草莓等多种特色高原作物。
“绿色种植与加工科技志愿服务团”隶属于昆明学院农学与生命科学学院的“云南高经济价值特色资源植物产业化开发应用创新团队”,主要由具有食品科学与工程专业背景的刘贺副教授(博士、硕导)与具有园艺作物栽培及植物保护专业背景的黄敏教授(博士、硕导)带队实地考察实验及合作基地的农产品种植及加工中出现的问题并找出解决方案。2022-2023年两年以来,团队志愿者在指导教师带队下,多次对公司种植基地及合作基地作物栽培管理、植保情况及后续加工处理中存在的问题进行调研,并与相关负责人进行交流,帮助农户梳理并解决种植及加工中遇到的各种问题。
图1 在校研究生注岀的公司
图2 公司简介
图3 团队成员调研百合种植情况
图4 团队成员现场调研草莓种植情况
二、师生“产学研用相结合”,针对种植基地农产品开发多种深加工食品及保鲜技术,并在实践基地进行转化,此外通过发表文章及申请专利形式对技术进行推广,以科技助力乡村振兴。
2021年4月,公司在云南省迪庆藏族自治州香格里拉市小中甸镇联合村委会如林村29号租地350亩建成“云南香格里拉奇异莓科技小院”乡村振兴实践基地。开展新型小浆果(奇异莓、黑树莓),水果甜百合、云南高寒地区夏秋绿色蔬菜等产业的产业化开发应用试验示范推广及乡村振兴服务实践工作。
(1)开展“点对点”技术指导,到云南耕雪农业科技有限公司及小中甸镇联合村开展农业科技服务。深入田间地头,针对特色小浆果及蔬菜的栽培及病虫害防治问题进行实地查看,提出建议和防治措施。
(2)创新服务方式方法、改进服务手段。重点围绕黑、红树莓,稀特蔬菜栽培管理及病虫害防控等方面做好服务,确保服务不因疫情而缺位。可通过以微信群发布作物管理技术要点,通过电话咨询答疑,或网上服务等方式帮助农民解决技术问题。
(3)与当地农技人员交流,了解当地急需解决的技术问题;定期为公司技术人员及农户开展农业普法培训;开展黑、红树莓,稀特蔬菜及当地主栽作物的栽培管理及病虫害防控技术培训。
根据农业绿色发展理念,立足我国当前化肥农药减施增效的战略需求及云南省优势特色农产品质量安全及生态环境安全,聚焦主要高附加值果树奇异莓、甜百合等作物化肥农药减施增效的重大任务,指导教师黄敏带领团队学生及公司技术人员开展田间调查、管理,以及相关绿色关键生产技术及病虫害绿色防控技术研究,已形成企业生产技术规程及有害生物综合防控策略,研究成果正在进行推广应用。推动企业及地区农业生产向产出高效、产品安全、资源节约、环境友好的农业现代化生产模式的转变。为公司及时解决作物种植过程中出现的有害生物危害的问题。
公司基地种植的软枣猕猴桃发生了叶部黑斑病,指导教师黄敏带领团队研究生对病害进行诊断、对病原进行了分离鉴定,以便进一步研究该病的有效防控方法。在为公司解决生产实践中出现的问题的同时,又培养了在校研究生在生产中发现问题、解决问题的能力。
图5 软枣猕猴桃黑斑病
图6 软枣猕猴桃黑斑病病叶上分离到的病原真菌
图7 为大棚种植的番茄出现的脐腐病提出绿色防控方案
图8 为百合种植中的病害问题提出微生物菌剂的防治方案
团队前期在乡村振兴服务站开展了引种及示范种植等工作,2022年挂果后,对后续产品保鲜及新型产品开发提出了要求,团队具有食品科学与工程专业背景的刘贺副教授(博士、硕导)带领志愿者团队在针对实验基地农产品原材料(藜麦、奇异莓、百合等)进行采样及原地检测后,开发了一系列保鲜及新型产品。
2年的志愿服务,主要的技术与产品如下:(1)针对于服务站种植的作物提出相关绿色关键生产技术,以及病虫害绿色防控技术措施。(2)对当地新发病害进行病原学、流行学研究,以及病害防控措施研究。(3)开发可食用喷涂保鲜剂配方两项(用于小浆果保鲜);(4)开发了一系列初加工产品(包括功夫藜麦米、干燥百合片、干燥玫瑰花等);(5)开发了一系列深加工产品(脱腥藜麦乳、发酵玫瑰花茶、藜麦营养棒、藜麦挂面、玫瑰藜麦布丁、猕猴桃果酒等)。基于产品发表研究论文两篇:(1)不同加工方法对墨红玫瑰花茶产品质量指标及酶活的影响及相关性分析[J].食品工业科技, 2023, 44(15): 337-345.(2)藜麦营养棒的加工工艺研究及其贮藏期间品质变化分析[J]. 粮食与油脂[J]. 2023, 36(03): 49-52。申请发明专利一项:一种高香气高营养价值玫瑰花花茶的加工方法[P]. 专利号: 202311358855.7. (发明专利)。
主要有两大收获及成效:(1)参与志愿服务达到师生丰富乡村振兴实践经验,增长服务能力和服务水平。(2)技术及产品通过企业及实践基地、合作基地进行落地,打造乡村振兴新兴支柱产业,带动农户增收。
图9 “云南香格里拉奇异莓科技小院”乡村振兴实践基地
图10 成果转化试验基地牌子
图11 不同发酵处理的玫瑰花茶产品
图12 部分产品图
图13 保鲜百合产品
图14 藜麦豆奶产品
图15 健康藜麦脆产品
三、志愿团队长期扎根乡村振兴服务实践基地,针对种植基地种植过程中出现的问题进行实地解决。
2022至2023年度,“绿色种植与加工科技志愿服务团”先后有10人在科技小院长期驻扎。两年来,志愿服务团队成员累计驻扎服务科技小院及周边农户约150天,与公司员工农户同吃、同住、同劳动。长驻志愿服务团成员主要开展科技成果转化试验示范推广服务、科技小院项目建设、完成毕业论文试验研究、服务乡村产业振兴等实践活动,成效显著,活动深受地方党委政府、企业、农户好评。
图16 志愿团队成员为村民开展培训
图17 志愿团队成员开展劳动实践
图18 成员开展科研实践活动
图19 地方党委政府到基地调研、指导工作
2.创新思路与特色做法
绿色种植与加工科技志愿服务团队充分发挥指导教师的专业优势,通过与农户及负责人交流与实地考察,直抓种植与生产中存在的技术难点、瓶颈问题,帮助农户解决实际问题,通过技术落地延长农产品加工产业链,从而达到提高农户收入的效果,以科技助力乡村振兴。
采取“校企合作”方式,在校内建成了“共建、共管、共享”的云南特色产业化关键技术体系研发联合实验平台;在校外云南省迪庆藏族自治州香格里拉市小中甸镇联合村委会如林村租地350亩建成“云南香格里拉奇异莓科技小院”乡村振兴志愿者实践基地。针对小浆果、藜麦、百合等种植及加工中农户遇到的实际问题,校内可开展较为基础理论性的研究,储备技术;校外可将理论研究结果及储备技术进行实地转化,以科技对乡村振兴进行了有力支撑。
服务团利用“科技小院”及乡村振兴实践平台,较好地实现“人才培养、科技创新、乡村振兴实践服务”三位一体的功效。通过师生参加乡村振兴志愿服务,一是使师生丰富了乡村振兴实践经验,通过与农户直接对话直面实际问题,拓宽了解决问题的思路,并增长了服务能力;二是使企业延长产业链,达成打造乡村振兴新兴支柱产业,推广辐射带动周边农户增收的目的;三是通过协调组织农户介入项目,农户通过参加基地劳务增收,提升村民产业技术技能,使用农民成长为产业乡土产业人才。
3.成果实效
目前,绿色种植与加工科技志愿服务团,“产教融合、产学研用相结合”,加工方面,已开展了多项保鲜及深加工技术研究,开发小浆果可食用保鲜剂配方两项,一系列初加工及深加工产品并已在实践及合作基地进行了落地,保鲜剂的使用可将小浆果的常温保鲜时间延长3天,初级加工产品(百合干、藜麦米)、深加工产品(藜麦挂面)等已落地开始售卖,产品供不应求,其他产品也在陆续准备落地;种植方面,围绕适宜云南高寒地区高经济价值植物优良品种引种试验、示范园建设项目,为200亩奇异莓(Kiwi berry)进行了标准化种植管理体系建设,从出现黑斑病的猕猴桃株分离到了病原菌并进行了鉴定,提出相应防控方案,有效防止了黑斑病的蔓延;为大棚种植的番茄出现的脐腐病提出了绿色防控方案。2022年至2023年两年间,通过乡村振兴实践志愿服务团产业技术培训为区域培养、储备了约40人的熟练农业产业技术人才队伍。志愿服务团的工作,深受地方党委政府好评和肯定。
绿色种植与加工科技志愿服务团,在“产教融合”,探索“新农科”人才培养方式,助力乡村振兴具有较好示范推广价值。2022年9月,项目被教育部办公厅、农业农村部办公厅、中国科协办公厅三部分联合认定为全国产教融合人才培养示范性“科技小院”;2022年10月,项目经中国高等教育学会组织专家实地走访认定论证后,授牌为全国“校企合作、双百计划”典型案例项目(云南省仅3项);2022年11月23日,国家教育部与省州市镇相关领导到本科技小院进行调研和指导工作。
图20 2022年11月23日,国家教育部与省州市镇领导到科技小院进行调研和指导工作
图21 三部联合授予的科技小院牌
图22 中国高等教育学会授牌
图23 志愿者服务基地牌
图24 教育部领导指导志愿服务成员
4.存在问题及建议
乡村振兴志愿服务实践基地,经费来源比较单一,完全依据企业和学校支持难度较大。另外协调师生长期驻点服务,需要强化多部协作,探索更加有效的管理运作模式,让志愿者同时能达成科技成果转化试验示范推广服务、科技小院项目建设、毕业论文试验研究、服务乡村产业振兴等实践活动的多重目标。真正达到充分利用“科技小院”及乡村振兴实践平台,实现“人才培养、科技创新、乡村振兴实践服务”三位一体的功效。